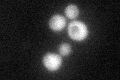
YNR034W
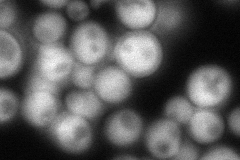
YNR034W
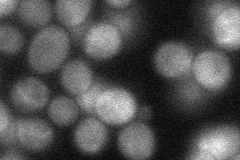
YNR034W
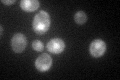
YNR034W

View description
Protein with a possible role in tRNA export; shows similarity to 6-phosphogluconolactonase non-catalytic domains but does not exhibit this enzymatic activity; homologous to Sol2p, Sol3p, and Sol4p
Localization:
Intensity:
Fold change:
Significance:
-
C’ GFP library in SD
cytosol43.51 -
N' NOP1pr-GFP in SD
cytosol111.492 -
N' TEF2pr-mCherry in SD

cytosol131.241 -
N' NATIVEpr-GFP in SD
cytosol33.2975 -
N' TEF2pr-VC and Cyto-VN in SD

cytosol57.6492 -
C’ GFP library in SD+DTT

cytosol47.021.08No -
C’ GFP library in SD+H2O2

cytosol54.441.25No -
C’ GFP library in Starvation Media
cytosol61.071.4Yes -
C’ GFP library on the background of Pup2-DaMP

cytosol -
C’ GFP library on the background of CCT mutant

cytosol60.52431.39091Yes
